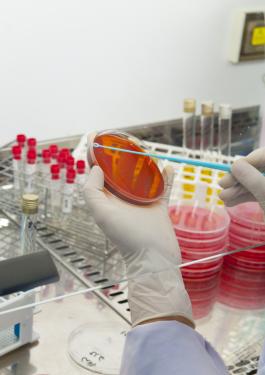
Food testing

production agricole
Agricultural
Production
ENSURE THE QUALITY OF YOUR PRODUCTION AND OPTIMIZE YOUR PRODUCTION YIELD
- Bureau Veritas has a global network of state-of-the-art laboratories specialised in the testing of agricultural products and fertilisers
- Bureau Veritas Network has grown considerably with the acquisition of Inspectorate (2010) and Maxxam (2014) and more recently, Dairy Technical Services in Australia (2016), Kuhlman in Brazil (2016), the Schutter Group (2017) and Labomag group in Morocco (2018)
- Bureau veritas will help you to fix your objectives and ensure the quality and quantity of your production
our OFFER
Why food production is emerging as a top sustainability issue ?
With the global population set to reach nearly 10 billion by 2050, the question of how to feed billions of people sustainably is becoming increasingly critical. Crop, livestock and fish farmers around the world are working to strike a responsible balance between meeting growing global demand, and protecting the environment.
Read more